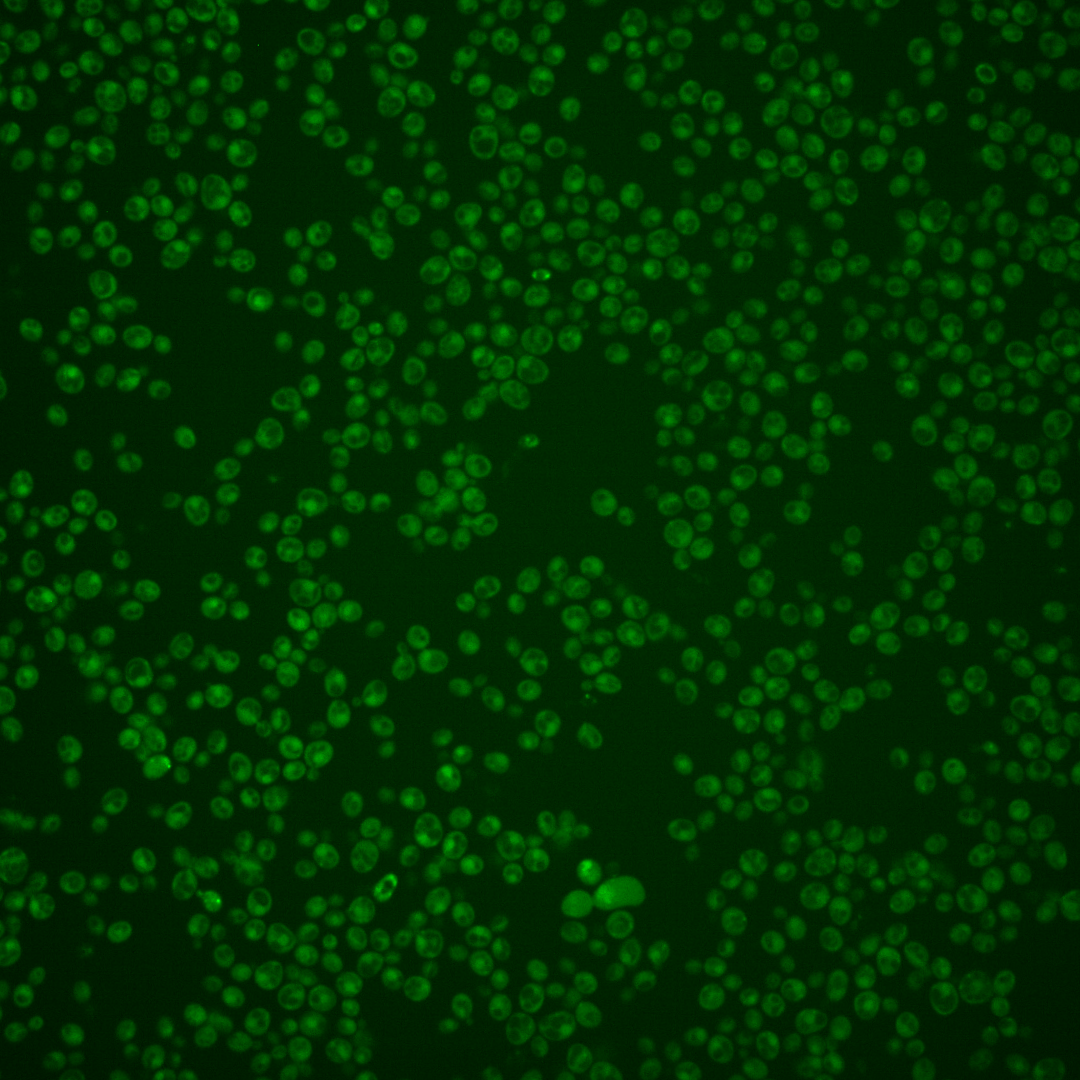
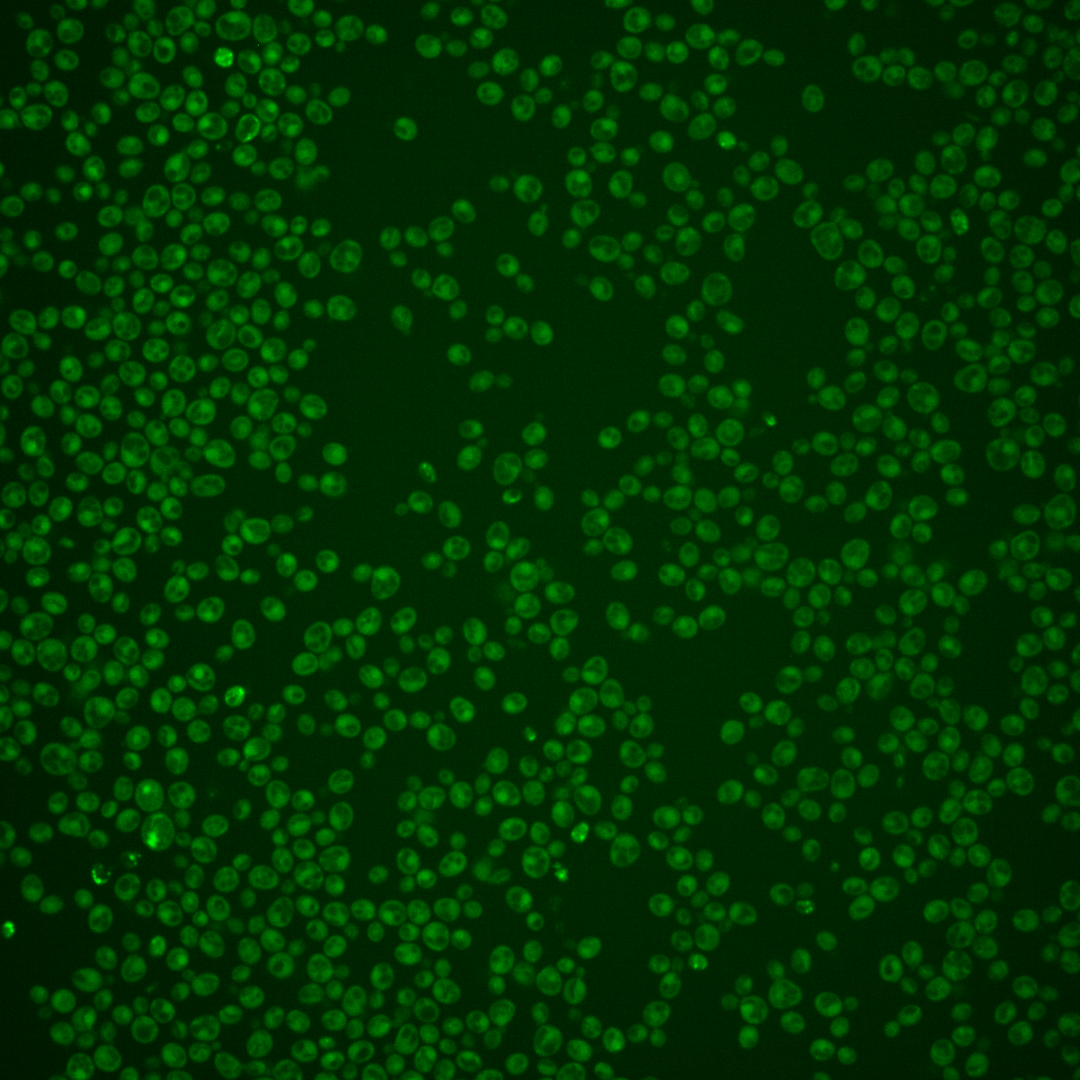
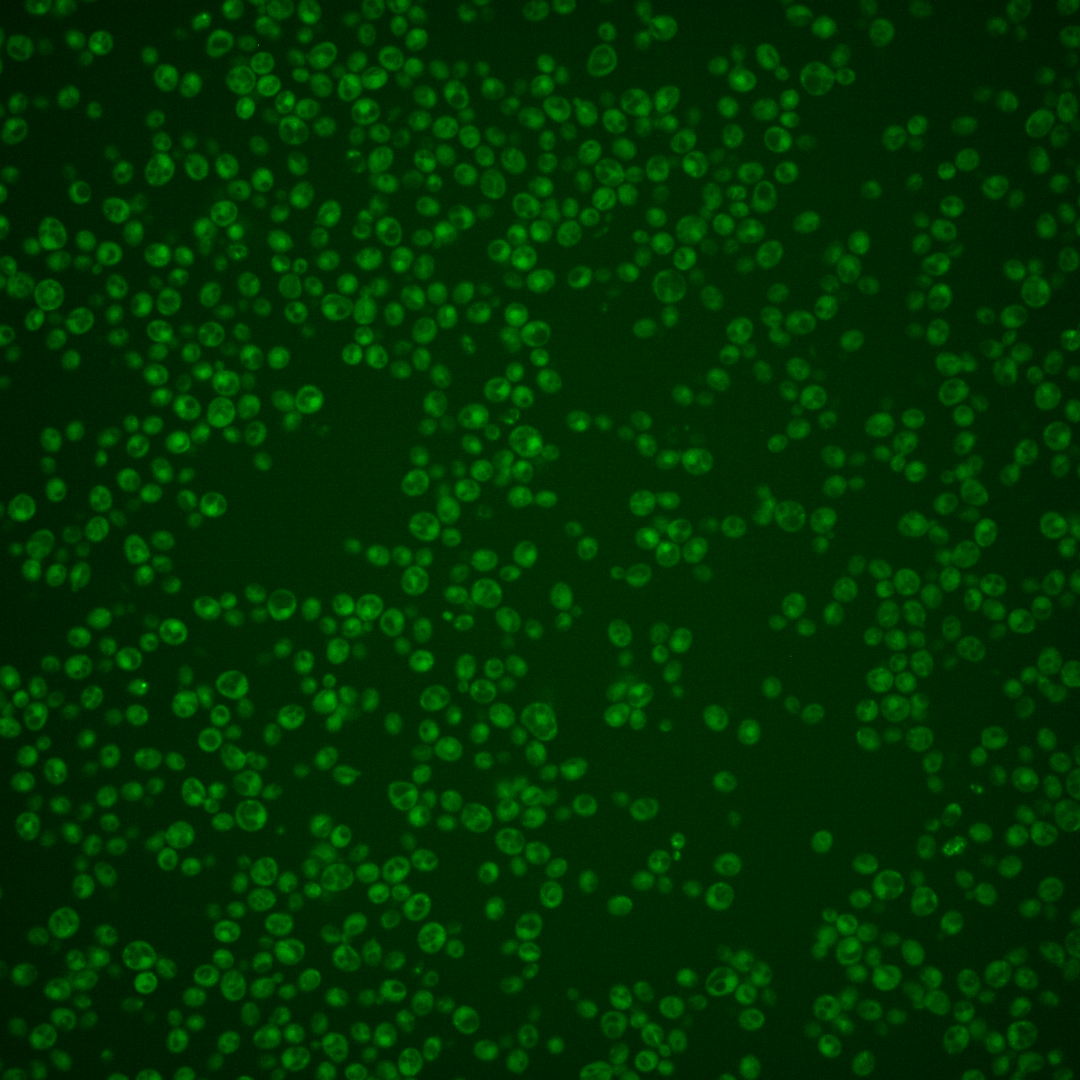
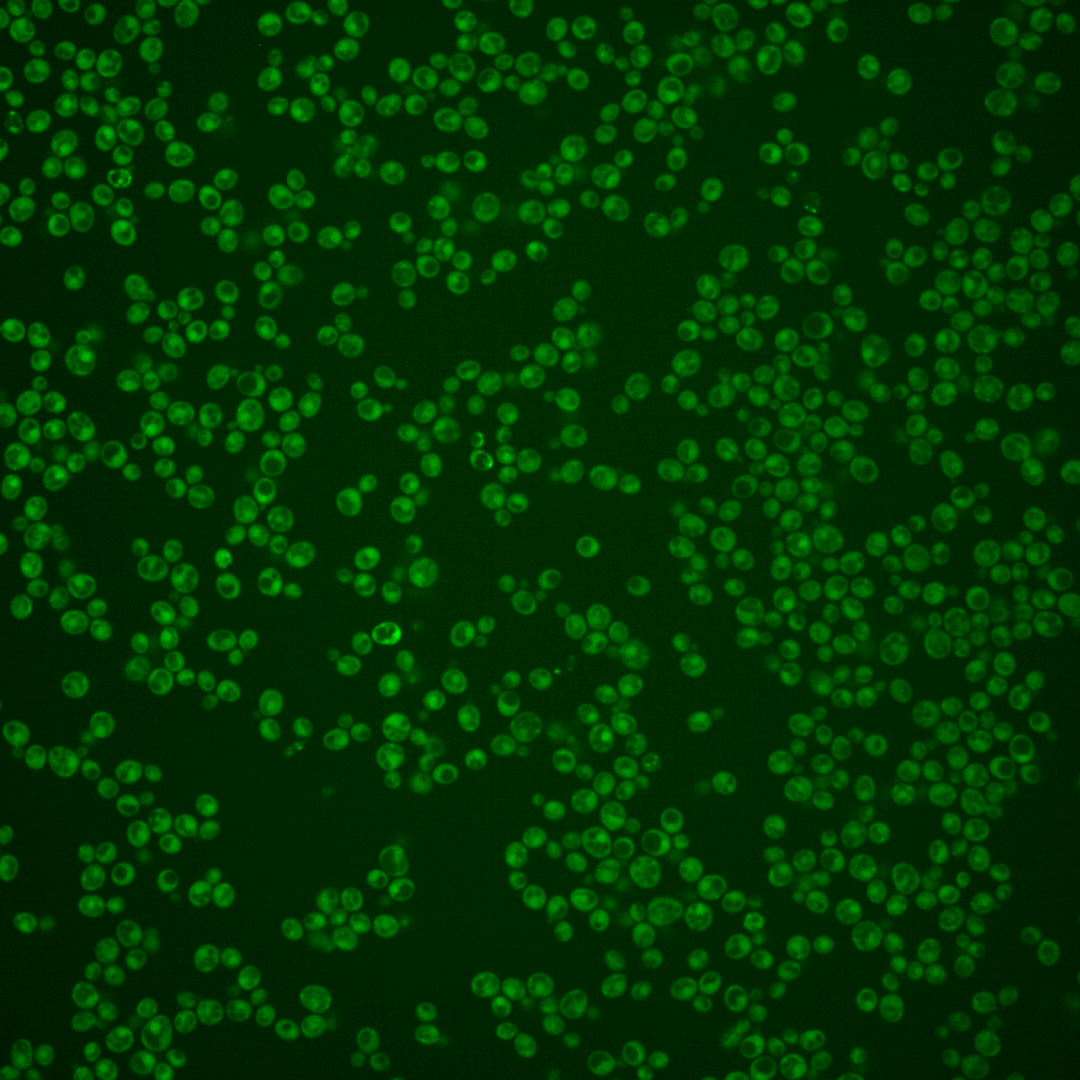
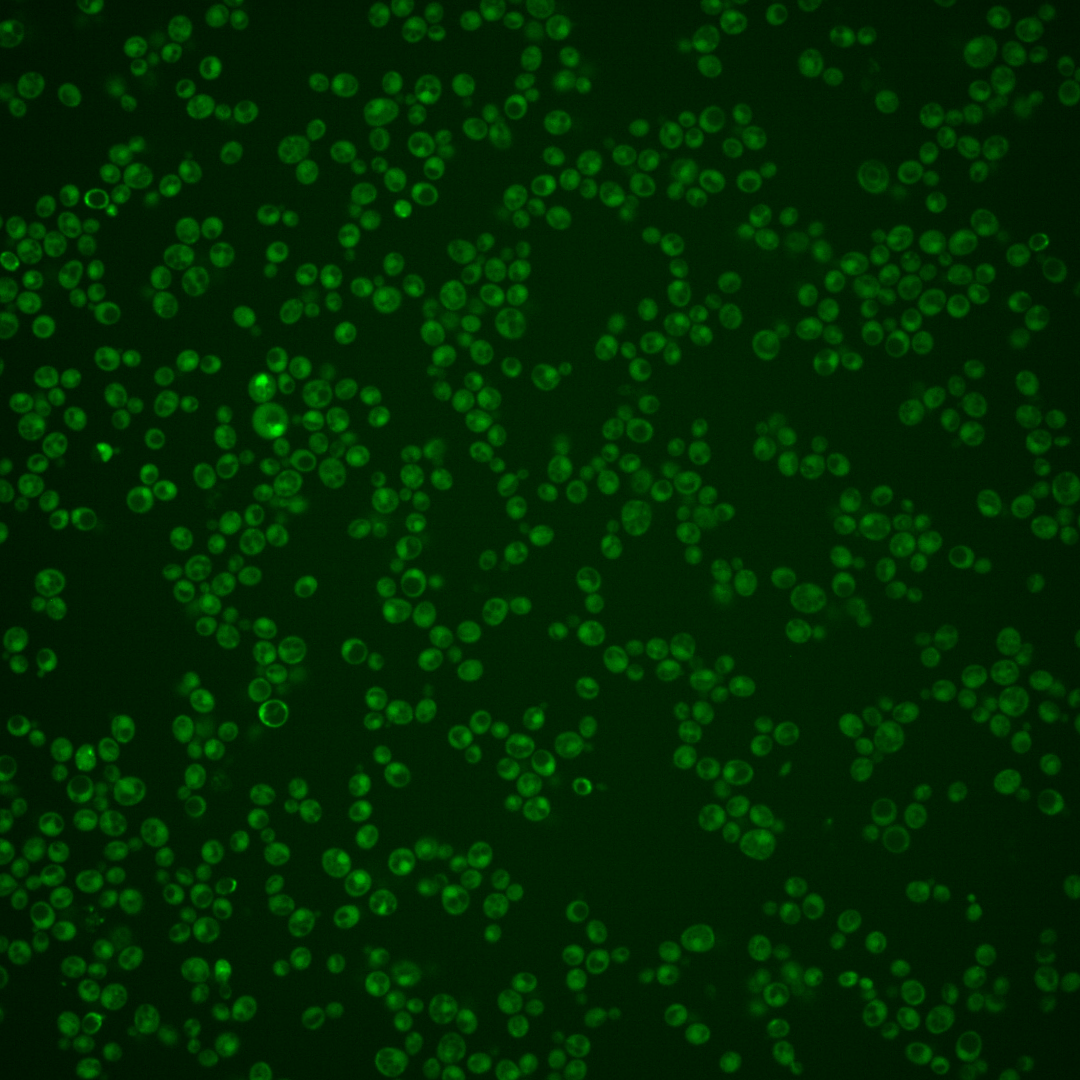

| Standard name | |
|---|---|
| Human Ortholog | |
| Description | Transcriptional regulator involved in the repression of GAL genes; involved in the repression of GAL genes in the absence of galactose; inhibits transcriptional activation by Gal4p; inhibition relieved by Gal3p or Gal1p binding |
Micrographs




















































































Sub-cellular Localization
Yeast GFP Assignment
Protein Abundance
Localization Change
External localization resources
| ensLOC | DeepLoc | |||||||||||||||||||||||
|---|---|---|---|---|---|---|---|---|---|---|---|---|---|---|---|---|---|---|---|---|---|---|---|---|
| Localization | WT1 | WT2 | WT3 | RAP60 | RAP140 | RAP220 | RAP300 | RAP380 | RAP460 | RAP540 | RAP620 | RAP700 | HU80 | HU120 | HU160 | rpd3Δ_1 | rpd3Δ_2 | rpd3Δ_3 | WT1 | WT2 | WT3 | AF100 | AF140 | AF180 |
| Cortical Patches | 1 | 0 | 0 | 0 | 0 | 0 | 0 | 0 | 0 | 0 | 0 | 0 | 0 | 0 | 0 | 1 | 0 | 0 | 1 | 6 | 13 | 3 | 1 | 3 |
| Bud | 2 | 3 | 3 | 2 | 6 | 13 | 30 | 20 | 20 | 28 | 33 | 16 | 0 | 0 | 0 | 0 | 1 | 1 | 0 | 15 | 7 | 2 | 5 | 7 |
| Bud Neck | 0 | 1 | 5 | 0 | 5 | 2 | 2 | 1 | 6 | 4 | 3 | 2 | 5 | 3 | 3 | 2 | 1 | 0 | 0 | 5 | 1 | 0 | 0 | 2 |
| Bud Site | 1 | 0 | 1 | 0 | 0 | 0 | 1 | 1 | 2 | 5 | 12 | 6 | 0 | 0 | 0 | 0 | 0 | 0 | – | – | – | – | – | – |
| Cell Periphery | 2 | 1 | 4 | 5 | 3 | 2 | 8 | 2 | 2 | 4 | 5 | 5 | 2 | 3 | 3 | 5 | 0 | 5 | 0 | 1 | 9 | 1 | 1 | 1 |
| Cytoplasm | 109 | 687 | 770 | 463 | 563 | 763 | 786 | 650 | 465 | 609 | 363 | 401 | 530 | 421 | 509 | 420 | 280 | 324 | 91 | 635 | 558 | 376 | 380 | 324 |
| Endoplasmic Reticulum | 0 | 3 | 0 | 0 | 1 | 0 | 0 | 0 | 0 | 0 | 0 | 3 | 0 | 2 | 3 | 42 | 9 | 24 | 3 | 0 | 11 | 0 | 1 | 3 |
| Endosome | 1 | 6 | 2 | 2 | 7 | 2 | 2 | 3 | 3 | 1 | 1 | 0 | 1 | 0 | 1 | 21 | 11 | 28 | 1 | 11 | 10 | 3 | 2 | 4 |
| Golgi | 0 | 1 | 0 | 0 | 0 | 0 | 0 | 0 | 0 | 0 | 0 | 0 | 0 | 0 | 0 | 1 | 1 | 2 | 0 | 0 | 0 | 1 | 2 | 0 |
| Mitochondria | 5 | 11 | 17 | 28 | 87 | 306 | 350 | 364 | 270 | 530 | 354 | 457 | 1 | 0 | 1 | 6 | 7 | 10 | 19 | 9 | 78 | 13 | 13 | 7 |
| Nucleus | 0 | 1 | 0 | 2 | 0 | 1 | 1 | 4 | 2 | 3 | 2 | 3 | 0 | 0 | 2 | 2 | 4 | 5 | 0 | 2 | 0 | 1 | 2 | 1 |
| Nuclear Periphery | 0 | 0 | 0 | 0 | 0 | 0 | 2 | 4 | 0 | 2 | 1 | 0 | 0 | 0 | 0 | 0 | 0 | 1 | 1 | 0 | 0 | 1 | 1 | 2 |
| Nucleolus | 0 | 0 | 0 | 0 | 1 | 1 | 1 | 2 | 1 | 0 | 0 | 0 | 0 | 0 | 0 | 1 | 0 | 1 | 0 | 0 | 2 | 0 | 0 | 0 |
| Peroxisomes | 0 | 0 | 1 | 0 | 0 | 0 | 2 | 0 | 0 | 0 | 0 | 0 | 0 | 0 | 0 | 0 | 0 | 1 | 0 | 1 | 0 | 0 | 0 | 0 |
| SpindlePole | 0 | 1 | 4 | 0 | 6 | 9 | 11 | 19 | 4 | 10 | 19 | 13 | 0 | 1 | 1 | 7 | 3 | 13 | 2 | 15 | 14 | 8 | 11 | 11 |
| Vac/Vac Membrane | 0 | 12 | 1 | 2 | 5 | 14 | 21 | 17 | 5 | 16 | 17 | 18 | 0 | 0 | 2 | 25 | 19 | 25 | 1 | 9 | 4 | 4 | 4 | 3 |
| Unique Cell Count | 113 | 715 | 782 | 475 | 600 | 889 | 977 | 884 | 631 | 937 | 611 | 739 | 531 | 424 | 515 | 470 | 315 | 380 | 131 | 728 | 740 | 427 | 439 | 380 |
| Labelled Cell Count | 121 | 727 | 808 | 504 | 684 | 1113 | 1217 | 1087 | 780 | 1212 | 810 | 924 | 539 | 430 | 525 | 533 | 336 | 440 | 131 | 728 | 740 | 427 | 439 | 380 |
Yeast GFP Assignment
Protein Abundance
| Screen | WT1 | WT2 | WT3 | RAP60 | RAP140 | RAP220 | RAP300 | RAP380 | RAP460 | RAP540 | RAP620 | RAP700 | HU80 | HU120 | HU160 | rpd3Δ_1 | rpd3Δ_2 | rpd3Δ_3 | AF100 | AF140 | AF180 |
|---|---|---|---|---|---|---|---|---|---|---|---|---|---|---|---|---|---|---|---|---|---|
| Mean Cell GFP Intensity (1e-4) | 3.0 | 4.3 | 3.6 | 3.4 | 3.6 | 3.2 | 3.1 | 3.1 | 3.0 | 2.7 | 2.6 | 2.7 | 5.1 | 5.1 | 4.9 | 5.8 | 5.3 | 5.5 | 5.2 | 5.5 | 5.8 |
| Std Deviation (1e-4) | 0.7 | 0.8 | 0.9 | 1.1 | 1.3 | 1.5 | 1.3 | 1.3 | 1.3 | 0.8 | 0.8 | 0.8 | 0.9 | 0.8 | 0.9 | 1.5 | 1.3 | 1.3 | 1.2 | 1.4 | 1.8 |
| Intensity Change (Log2) | – | – | – | -0.08 | -0.02 | -0.18 | -0.2 | -0.22 | -0.25 | -0.4 | -0.48 | -0.42 | 0.51 | 0.49 | 0.43 | 0.69 | 0.56 | 0.62 | 0.53 | 0.62 | 0.68 |
Localization Change
| Localization | RAP60 | RAP140 | RAP220 | RAP300 | RAP380 | RAP460 | RAP540 | RAP620 | RAP700 | HU80 | HU120 | HU160 | rpd3Δ_1 | rpd3Δ_2 | rpd3Δ_3 |
|---|---|---|---|---|---|---|---|---|---|---|---|---|---|---|---|
| Actin | – | – | – | – | – | – | – | – | – | – | – | – | – | – | – |
| Bud | – | – | – | – | – | – | – | – | – | – | – | – | 0 | 0 | 0 |
| Bud Neck | – | – | – | – | – | – | – | – | – | – | – | – | 0 | 0 | 0 |
| Bud Site | – | – | – | – | – | – | – | – | – | – | – | – | 0 | 0 | 0 |
| Cell Periphery | – | – | – | – | – | – | – | – | – | – | – | – | 0 | 0 | 0 |
| Cyto | – | – | – | – | – | – | – | – | – | – | – | – | – | – | – |
| Endoplasmic Reticulum | – | – | – | – | – | – | – | – | – | – | – | – | 0 | 0 | 0 |
| Endosome | – | – | – | – | – | – | – | – | – | – | – | – | 0 | 0 | 0 |
| Golgi | – | – | – | – | – | – | – | – | – | – | – | – | 0 | 0 | 0 |
| Mitochondria | – | – | – | – | – | – | – | – | – | – | – | – | 0 | 0 | 0 |
| Nuclear Periphery | – | – | – | – | – | – | – | – | – | – | – | – | 0 | 0 | 0 |
| Nuc | – | – | – | – | – | – | – | – | – | – | – | – | – | – | – |
| Nucleolus | – | – | – | – | – | – | – | – | – | – | – | – | 0 | 0 | 0 |
| Peroxisomes | – | – | – | – | – | – | – | – | – | – | – | – | 0 | 0 | 0 |
| SpindlePole | – | – | – | – | – | – | – | – | – | – | – | – | 0 | 0 | 0 |
| Vac | – | – | – | – | – | – | – | – | – | – | – | – | – | – | – |
| Cortical Patches | – | – | – | – | – | – | – | – | – | – | – | – | 0 | 0 | 0 |
| Cytoplasm | – | – | – | – | – | – | – | – | – | – | – | – | 0 | 0 | 0 |
| Nucleus | – | – | – | – | – | – | – | – | – | – | – | – | 0 | 0 | 0 |
| Vacuole | – | – | – | – | – | – | – | – | – | – | – | – | 6.2 | 6.6 | 7.0 |
External localization resources
Images






























Protein Concentration and Protein Localization Data
| R1 | R2 | R3 | ||||||||||||||||
|---|---|---|---|---|---|---|---|---|---|---|---|---|---|---|---|---|---|---|
| G1 Pre-START | G1 Post-START | S/G2 | Metaphase | Anaphase | Telophase | G1 Pre-START | G1 Post-START | S/G2 | Metaphase | Anaphase | Telophase | G1 Pre-START | G1 Post-START | S/G2 | Metaphase | Anaphase | Telophase | |
| Concentration | 2.1363 | 2.9621 | 2.5064 | 2.3179 | 2.0816 | 2.6135 | -0.4019 | -0.0924 | -0.3343 | -0.1832 | -0.0057 | -0.1654 | -0.7341 | -0.1375 | -0.4079 | -0.5528 | -0.9968 | -0.34 |
| Actin | 0.0002 | 0.0002 | 0.0003 | 0.0013 | 0.0001 | 0.0002 | 0.0176 | 0.0001 | 0.0002 | 0.0016 | 0.0008 | 0.0007 | 0.0071 | 0.0001 | 0.0005 | 0.0009 | 0.0006 | 0.0003 |
| Bud | 0.0013 | 0.0001 | 0 | 0.0003 | 0 | 0.0036 | 0.0004 | 0.007 | 0.0025 | 0.0012 | 0.0021 | 0.0015 | 0.0004 | 0 | 0.0005 | 0.0019 | 0 | 0.0001 |
| Bud Neck | 0.0002 | 0 | 0.0001 | 0.0237 | 0 | 0.0001 | 0.0042 | 0.0002 | 0.001 | 0.0224 | 0.0002 | 0.0007 | 0.0005 | 0 | 0.0001 | 0.0004 | 0 | 0.0001 |
| Bud Periphery | 0.0005 | 0.0001 | 0.0001 | 0.0005 | 0 | 0.001 | 0.0008 | 0.002 | 0.0011 | 0.0046 | 0.0025 | 0.0008 | 0.0007 | 0 | 0.0005 | 0.0024 | 0 | 0.0001 |
| Bud Site | 0.0014 | 0.0001 | 0.0004 | 0.0002 | 0 | 0 | 0.0016 | 0.0158 | 0.0056 | 0.0063 | 0.0004 | 0.0002 | 0.0056 | 0.0003 | 0.0009 | 0.0004 | 0 | 0 |
| Cell Periphery | 0.0001 | 0.0001 | 0.0001 | 0.0001 | 0 | 0 | 0.0005 | 0.0004 | 0.0001 | 0.0018 | 0.0001 | 0.0001 | 0.0002 | 0 | 0.0001 | 0.0002 | 0 | 0 |
| Cytoplasm | 0.0338 | 0.0645 | 0.073 | 0.0509 | 0.0299 | 0.0625 | 0.0818 | 0.0897 | 0.0875 | 0.1014 | 0.0598 | 0.1004 | 0.045 | 0.1049 | 0.1041 | 0.1063 | 0.1003 | 0.1276 |
| Cytoplasmic Foci | 0.0148 | 0.0026 | 0.0113 | 0.0061 | 0.0012 | 0.006 | 0.016 | 0.0041 | 0.0056 | 0.0043 | 0.005 | 0.0098 | 0.004 | 0.0061 | 0.0033 | 0.0057 | 0.0064 | 0.0083 |
| Eisosomes | 0.0003 | 0.0003 | 0.0003 | 0.0001 | 0 | 0.0001 | 0.0003 | 0.0001 | 0.0001 | 0.0001 | 0.0001 | 0 | 0.0003 | 0.0001 | 0.0001 | 0.0002 | 0.0001 | 0.0001 |
| Endoplasmic Reticulum | 0.0007 | 0.0014 | 0.001 | 0.0004 | 0.0003 | 0.0003 | 0.0034 | 0.0006 | 0.0008 | 0.0011 | 0.0008 | 0.0007 | 0.0008 | 0.0009 | 0.0008 | 0.0015 | 0.0019 | 0.0005 |
| Endosome | 0.0008 | 0.0017 | 0.0007 | 0.0004 | 0.0001 | 0.0002 | 0.008 | 0.0008 | 0.0012 | 0.0015 | 0.0005 | 0.0012 | 0.0056 | 0.0033 | 0.0006 | 0.0012 | 0.0017 | 0.0034 |
| Golgi | 0.0001 | 0.0001 | 0.0002 | 0.0001 | 0 | 0 | 0.0013 | 0.0001 | 0.0001 | 0.0003 | 0.0001 | 0.0001 | 0.0006 | 0.0001 | 0.0001 | 0.0002 | 0.0001 | 0.0001 |
| Lipid Particles | 0.0005 | 0.0005 | 0.001 | 0.0001 | 0.0001 | 0.0001 | 0.002 | 0.0001 | 0.0002 | 0.0003 | 0.0003 | 0.0009 | 0.0024 | 0.0002 | 0.0001 | 0.001 | 0.0002 | 0.0005 |
| Mitochondria | 0.002 | 0.0006 | 0.0002 | 0.0002 | 0.0001 | 0.0004 | 0.0012 | 0.0003 | 0.0004 | 0.0006 | 0.0005 | 0.0004 | 0.0005 | 0.0001 | 0.0003 | 0.0005 | 0.0001 | 0.0001 |
| None | 0.913 | 0.9254 | 0.9065 | 0.8892 | 0.9674 | 0.9236 | 0.8344 | 0.8735 | 0.8865 | 0.8344 | 0.9192 | 0.8714 | 0.9185 | 0.8815 | 0.8857 | 0.8637 | 0.8861 | 0.8556 |
| Nuclear Periphery | 0.0004 | 0.0005 | 0.0002 | 0.0002 | 0.0001 | 0.0001 | 0.0058 | 0.0003 | 0.0005 | 0.0021 | 0.0012 | 0.0008 | 0.0006 | 0.0005 | 0.0004 | 0.0013 | 0.0006 | 0.0002 |
| Nucleolus | 0.0014 | 0.0001 | 0.0002 | 0.0003 | 0 | 0.0001 | 0.0024 | 0.0004 | 0.0006 | 0.0008 | 0.0005 | 0.0003 | 0.0016 | 0.0001 | 0.0001 | 0.0009 | 0.0001 | 0.0001 |
| Nucleus | 0.019 | 0.0005 | 0.0006 | 0.0018 | 0.0001 | 0.0008 | 0.0052 | 0.0021 | 0.0031 | 0.0038 | 0.0015 | 0.0019 | 0.0006 | 0.0006 | 0.0007 | 0.0041 | 0.0006 | 0.0006 |
| Peroxisomes | 0.0003 | 0.0001 | 0.0004 | 0.0001 | 0.0001 | 0 | 0.0014 | 0.0001 | 0.0002 | 0.0003 | 0.0003 | 0.0032 | 0.0006 | 0 | 0.0001 | 0.0004 | 0.0001 | 0.0001 |
| Punctate Nuclear | 0.0088 | 0.0003 | 0.0024 | 0.0237 | 0.0001 | 0.0006 | 0.0097 | 0.0016 | 0.0023 | 0.0095 | 0.0031 | 0.0043 | 0.0004 | 0.0009 | 0.0007 | 0.0059 | 0.0008 | 0.0014 |
| Vacuole | 0.0005 | 0.0007 | 0.001 | 0.0003 | 0.0001 | 0.0002 | 0.0015 | 0.0006 | 0.0005 | 0.0016 | 0.0007 | 0.0003 | 0.0036 | 0.0003 | 0.0003 | 0.0008 | 0.0003 | 0.0006 |
| Vacuole Periphery | 0.0001 | 0.0001 | 0 | 0 | 0 | 0 | 0.0005 | 0.0001 | 0.0001 | 0.0003 | 0.0002 | 0.0001 | 0.0004 | 0 | 0.0001 | 0.0002 | 0 | 0.0001 |
Sequencing Data
| R1 | R2 | |||||||||
|---|---|---|---|---|---|---|---|---|---|---|
| G1 Post-START | S/G2 | Metaphase | Anaphase | Telophase | G1 Post-START | S/G2 | Metaphase | Anaphase | Telophase | |
| Gene Expression | 35.8522 | 24.1315 | 23.5025 | 36.151 | 37.1872 | 37.097 | 30.3086 | 29.5908 | 25.2511 | 41.2162 |
| Translational Efficiency | 0.1275 | 0.1257 | 0.1275 | 0.0855 | 0.0747 | 0.1032 | 0.1242 | 0.1125 | 0.1328 | 0.0874 |
Hit Data
| Dataset | Hit |
|---|---|
| Protein Concentration | ✘ |
| Protein Localization | ✘ |
| Gene Expression | ✘ |
| Translational Efficiency | ✘ |
Endocytosis
| Temp | Actin Patch (Sac6-tdTomato) | Cortical Patch (Sla1-GFP) | Late Endosome (Snf7-GFP) | Vacuole (Vph1-GFP) |
|---|---|---|---|---|
| 37℃ | ||||
| RT |
Cell Cycle Omics
CYCLoPs (Gal80-GFP)
| Gene / Allele | Actin Patch (Sac6-tdTomato) | Cortical Patch (Sla1-GFP) | Late Endosome (Snf7-GFP) | Vacuole (Sac6-tdTomato) |
|---|
| Gene | Images |
|---|
| Gene | Images |
|---|
Images are not yet available
Images are not yet available